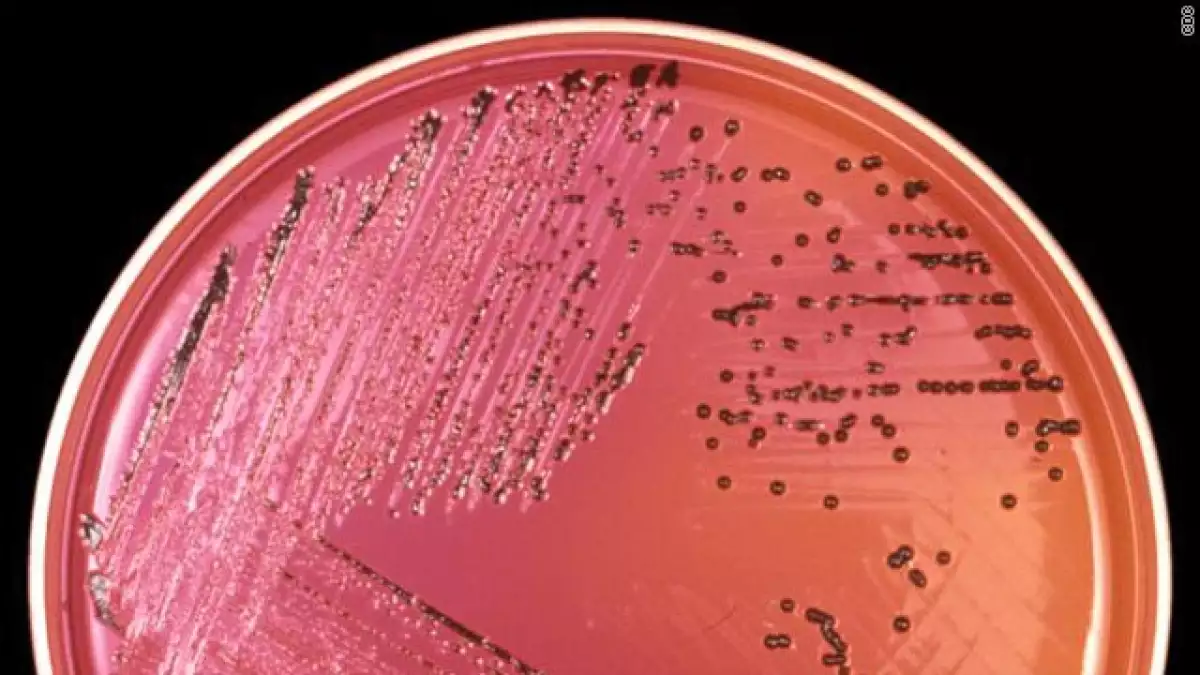

Qué es la salmonelosis y cómo puedes prevenirla
La salmonela es un tipo de bacteria que se encuentra en los tractos intestinales de los humanos y otros animales. Los humanos pueden contraer la salmonelosis, la infección vinculada a la salmonela, cuando comen alimentos contaminados con heces animales. Probablemente no te des cuenta de esa contaminación al verla u olerla.
La carne, las aves, leche y quesos son fuentes comunes, pero puedes contraer salmonelosis con cualquier alimento, incluidos los vegetales.
La bacteria muere en la cocción de los alimentos, pero si un portador de la infección no se lava las manos después de usar el baño, cualquier alimento que él o ella toque se contaminará.
Síntomas
Diarrea, fiebre y dolores abdominales son comunes entre 12 y 72 horas después de que la persona resultó infectada y se recupera de 4 a 7 días sin tratamiento.
Pero algunas veces, la salmonelosis se extiende desde los intestinos hacia el flujo sanguíneo y a otras zonas del cuerpo. En este caso, una persona podría morir a menos que reciba antibióticos. La gente con inmunodeficiencia y la gente mayor e infantes son más propensos a enfermarse con más gravedad.
Complicaciones a largo plazo
La gente que tiene diarrea normalmente se recupera completamente, pero sus hábitos intestinales pueden no regresar a la normalidad por varios meses. En un pequeño número de casos, la gente podría experimentar dolor en articulaciones, irritación de ojos y expulsión dolorosa de la orina, una condición llamada Síndrome de Reiter. Esto puede durar por meses o años.
Tratamiento
La mayoría de la gente se recupera de la infección entre cuatro y siete días y únicamente necesita líquidos. Algunas bacterias de la salmonela son resistentes a los antibióticos.
Prevención
Asegurarse de cocinar toda la carne y huevos de aves de corral . No comer o beber nada con huevo crudo o leche no pasteurizada.
En un restaurante regresar los alimentos poco cocidos, aves, carne o huevos.
Lavarse las manos, los utensilios y la superficie de la cocina con agua y jabón después de haber tocado carne cruda o aves.
Tener especial atención en los alimentos para los niños, los adultos mayores y gente con sistemas de inmunidad deficientes.
Siempre lavarse las manos después de tocar a un reptil o a un ave, incluso si aparentan estar saludables. Algunas heces de las mascotas pueden contener salmonela, especialmente la de los reptiles.
Asegurarse que los niños o las personas con inmunodeficiencia no entren en contacto indirecto con reptiles.
No alimentar o cambiar de pañal a un bebé cuando se está en contacto con carne de ave o roja cruda.
La leche materna es el alimento más seguro para los bebés y previene la salmonelosis, además de otras enfermedades.